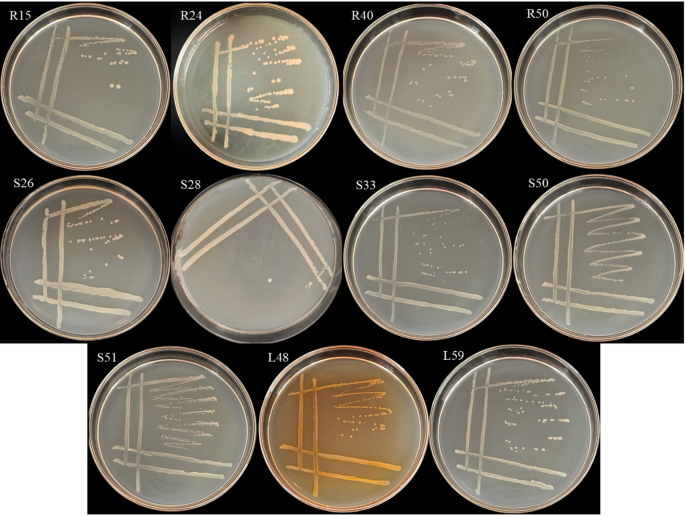
figure 2

Abstract
Shengli grass has attracted growing attention in the fields of functional foods and medicines due to its widely reported healing effects, yet its chemical components and the potential mechanisms underlying its health benefits to humans remain insufficiently elucidated. This study employed headspace solid-phase microextraction coupled with gas chromatography-mass spectrometry (HS-SPME-GC-MS) to determine the volatile components (VOCs), extract components of Shengli Grass, and secondary metabolites of 11 endophytes isolated from it. Active components were screened, their biological targets identified via combined targeted fishing, and network-based analysis was conducted among active components, targets, enrichment pathways, and diseases to explore the potential molecular mechanisms of Shengli Grass in anti-inflammatory and antibacterial activities.A total of 100 VOCs, 51 extract components, and 24 endophyte secondary metabolites were identified. Olefins (e.g., selina-3,7(11)-diene, m-cymene) were the most abundant in Shengli Grass, followed by esters (e.g., linalyl propionate); endophyte secondary metabolites also had high ester content, with 29% of components overlapping with those of Shengli Grass. After screening via the TCMSP database, 110 chemical components (81 VOCs, 29 extract components) and 20 secondary metabolites were selected for network pharmacology, corresponding to 418 and 223 targets, respectively.Geranyl isobutyrate, neryl acetate, and neryl formate were proposed as the main anti-bacterial and anti-inflammatory components. GO function and KEGG pathway enrichment analyses of common targets revealed that Shengli Grass might exert its effects via pathways such as cancer, endocrine resistance, lipid and atherosclerosis, phosphorylation, xenobiotic stimulus response, calcium signaling, and protein phosphorylation; key targets included ALB, AKT1, EGFR, SRC, ESR1, and NFKB1.In conclusion, Shengli Grass exerts anti-inflammatory and antibacterial effects through multi-component, multi-target, and multi-pathway involvement in biological processes, providing a theoretical basis for its development and utilization.
Introduction
Shengli grass, a perennial medicinal herb of the genus Eupatorium in the Asteraceae family, which is widely distributed and rooted in the Yellow River basin of eastern Henan Province, has smooth stems and blooms in autumn1. The whole plant has a fragrant scent, and the aroma is stronger when rubbed2. Shengli grass has many pharmacological activities such as antibacterial, anti-inflammatory and immunity-enhancing activities. According to the existing literature, Shengli grass can not only improve the cellular immunity of mice,1,3 but also have anti-fatigue functio2. The acute toxicity test on broilers showed that the herb is actually a non-toxic substance, which can promote fat metabolism, prevent and treat infectious bronchitis in chickens artificially infected4,5,6. Xu et al.7 found that the extract of Shengli grass had inhibitory effect on Escherichia coli, which indicated that the herb has great medicinal value and edible development prospects. However, there has been no recent study on the chemical constituents of Shengli grass.
The production of endophytic active substances is related to the physiological functions of endophytes. Studies have shown that when endophytes promote the synthesis of secondary metabolites in the host, the host does not simply increase the content of substances, but triggers biochemical processes in the body (such as promoting growth and regulating stress resistance) through endophytes. One of the promoting mechanisms is that endophytes form the same signal pathways as the host through gene mutation or information exchange, thereby producing secondary metabolites similar to those of the host. For example, endophytes isolated from peanut can produce the same ACC-deaminase and IAA as their host8. Another way is that endophytes cooperate with their hosts to complete a process of the same signal pathway, which may produce key enzymes in the pathway, or change a reaction direction in the process of host metabolism to make their hosts produce specific metabolites (Fig. 1).
Studies based on metabolomics have also shown that endophytes are repositories of bioactive metabolites that can produce many active products with pharmacological effects, such as antimicrobial, antitumor, antibiotic, antioxidant, and immune agents9. Endophytes produce bioactive compounds, but obtaining these solely from them is unrealistic, as their beneficial products are affected by host and environmental factors.In fact, the active products of endophytes can solve the shortage of natural resources and provide new age ideas for the development and preparation of new drugs, but current research on endophytes is far from reaching this goal.Currently, although some endophytic strains capable of producing the active metabolites of their hosts have been isolated, these strains are almost impossible to apply in practical production due to the great difficulty in in vitro culture. Therefore, the in vitro culture and propagation of host endophytes, as well as the large-scale production of their active components, are core challenges faced by current applied research. They also serve as the prerequisite for endophytes to replace medicinal plants and achieve the commercial production of high-quality pharmacodynamically active components10. Based on the concept of network pharmacology, this study predicts the common metabolic pathways or interactive metabolic pathways between endophytes and their host plants, so as to promote research on the in vitro culture and propagation of endophytes and the large-scale production of their active components.
Endophyte induced secondary metabolites and their biological activities during plant–endophyte interaction.
Materials and methods
Materials
Shengli grass samples were collected from Shengli grass planting base in Shangqiu City, Henan Province. The specific sampling information was shown in the Table 1. Sample collection adopts five-point sampling method, and the spacing between each sampling point is more than 50 m. After the samples were collected, they were put into sealed bags and stored in the refrigerator at 4℃ for later use.
Methods
Isolation, purification and identification of endophytic bacteria from Shengli grass
Fresh roots, stems and leaves of Shengli grass with a weight of 1 g was precisely weighed and then thoroughly rinsed with flowing tap water. Subsequently, the surface moisture was carefully dried using sterile filter paper, following which the samples were placed into a super-clean workbench (DJ-CJ-2NDI clean bench, Beijing Donglian Hall Instrument Manufacturing Co., Ltd.). The samples were rinsed five times with sterile water, soaked in a 4.5% sodium hypochlorite solution for a duration of three minutes, and then rinsed another five times with sterile water. After that, they were immersed in 75% ethanol for five minutes and finally rinsed eight times with sterile water. The plant tissues were meticulously cut into small pieces approximately measuring 0.3 cm×0.2 cm in size with sterilized scissors and then transferred into a sterile mortar. Sterile water with a volume of 9mL was added, and the materials were ground into slurry. After standing for a while, the supernatant was aspirated and diluted with sterile water to achieve gradient concentrations of 10⁻¹, 10⁻², 10⁻³ and 10⁻⁴ respectively. Subsequently, 100µL of each diluted sample was carefully aspirated and evenly spread onto beef paste peptone culture medium, with three culture plates prepared for each concentration. Meanwhile, the last rinse solution was taken and spread as a blank control to ascertain the thoroughness of the surface disinfection. The plate coated with tissue grinding liquid was inverted in a constant temperature incubator (ZHPW-250 horizontal constant temperature oscillation incubator, Tianjin Laiboteli Instrument Equipment Co., Ltd.) set at 37℃ and left for 24 ~ 72 h. After bacterial colonies had grown, a single colony was carefully selected and subjected to streaking purification culture. This streaking process could be repeated 2 ~ 3 times until a pure single colony was obtained.
The genomic DNA of 11 endophytic bacteria was extracted by CTAB11 method and amplified by PCR. The phylogenetic relationships of endophytes were analyzed by performing Illumina high-throughput sequencing on the V3-V5 conserved variable regions of the 16 S rRNA gene. Individual isolates were identified based on a BLAST search. The gene sequences were submitted to NCBI GenBank and accession numbers were assigned. The sequences were aligned by ClustalW using MEGA 4.0 software and a neighbor-joining (NJ) phylogenetic tree with a bootstrap value 1000 was generated.
Determination of volatile organic compounds
The VOCs in the samples were extracted through headspace solid phase microextraction (HS-SPME) and identified using the GC-MS method (8890 − 7000, Agilent, USA). The method is based on the description by Prateek Gupta12. Roots, stems and leaves of Shengli grass were washed with distilled water, dried, weighed into 0.5 g to 20mL headspace screw bottles respectively. In the experiment, each sample was treated three times to ensure the reproducibility of the results.A control group was set up with no sample added. The 80/100µm DVB/CWR/PDMS Solid Phase Microextraction head extraction head was inserted into the headspace screw bottle for headspace extraction at 60℃ for 10 min. The extraction head was inserted into the chromatograph sample inlet for desorption, desorption temperature was 230 °C, desorption time was 3 min. The chromatographic column was HP-5MS (30 mm×0.25 mm×0.25 mm) elastic quartz capillary tube; carrier gas: helium (purity > 99.9995%); flow rate: 1.0 ml/min; Sampling temperature: 230 °C; the split ratio was 10:1. The initial temperature of the chromatographic column was set at 40 °C, and then it was raised to 80 °C at 10 cm in for 3 min. After that, it was raised to 190 °C at 3 cm in, and then it was raised to 240 °C at 115 °C・min⁻¹ for 5 min. Full-scan mode was adopted, 70 eV EI ionization was applied, and the mass range of full-scan method was set to 35 ~ 450Da. The interface temperature was 250 °C, and the temperature of transmission line and ion source was set to 250 °C.
Determination of chemical constituents in the extract of Shengli grass
The cleaned roots, stems and leaves of Shengli grass were baked in an oven at 80℃ for 48 h, then crushed, sieved with a 40-mesh sieve and stored at 4℃ for later use. Ten grams of roots, stems and leaves powder was accurately weighed, put in a triangular flask, and then 100mL of pure water was added to extract them for 72 h in the dark, filter, concentrate the extract by rotary evaporation (RE-2000B, Zhengzhou Huachen Instrument Co., LTD), and freeze-dry in vacuum (SUPERMODUL YO-230Vacuum Freeze-Dryer, Thermo). The frozen dry powder was completely dissolved in ethyl acetate to extract non-polar substances. Filtered with 0.22 μm membrane, and injected with 2µL filtrate13. Each sample was treated in triplicate.A control group was set up with ethyl acetate alone and no sample added.
Root, stem and leaf extracts were analyzed by GC-MS. SH-RXI-5 MS (30 m×250 μm×0.25 μm) was used as the chromatographic column. Heating program: the initial temperature is 60℃ for 3 min, then it is raised to 100℃ at the rate of 3℃/min for 3 min, then to 200℃ at the rate of 8℃/min for 8 min, and then to 250℃ at the rate of 5℃/min for 10 min; the carrier gas is helium, the flow rate of the carrier gas is 1mL/min, the temperature of the injection port is 250℃, and the injection volume is 1.0µL without shunting. Mass spectrometry conditions: ionization mode EI; electron energy 70 eV; the ion source temperature is 230℃; and the scanning quality range is 40 ~ 500Da14.
Determination of secondary metabolites of endophytic bacteria in Shengli grass
Inoculated the purified strains were placed into 1 mL LB liquid culture medium, shook cultured at 28℃ and 180 r/min for 24 h to obtain seed liquid. Then inoculated 0.5 mL into 100 mL LB liquid culture medium, the control was the LB medium solution without inoculation. And shook culture at 28℃ and 180r/min for 48 h to obtain strain fermentation liquid. It was concentrated and dried under reduced pressure, fully dissolved with ethyl acetate, and centrifuged (JW-3024 h, Anhui Jiawen Instrument Equipment Co., Ltd.) at 10000r/min for 10 min, and 0.25mL supernatant was collected. Three replicates were set for each sample. The GC-MS analysis adopted the same procedure as that used for detecting the active components in the ethyl acetate extract of Shengli grass15.
Network pharmacology analysis of active ingredients in Shengli grass
Screening of active components and targets of Shengli grass
The main active components were screened from the chemical components of Senecio japonicus by TCMSP (https://www.tcmsp-e.com/) database, and the comprehensive target prediction method was adopted: components searched by component name or CAS number, TCMSP, TTD (https://db.idrblab.net/ttd) database or compound SMILES number obtained through PubChem (https://pubchem.ncbi.nlm.nih.gov/) database were input into Swiss Target Prediction (http://swisstargetprediction.ch/) database, standardized by “Homosapiens”. Meanwhile, the target of active chemical components of lycopodium japonicum was searched and screened, the potential target data set of active components was established, and the screened targets were converted into gene names through UniProt (https://www.uniprot.org/) database query16.
Screening of disease-related targets
Screening of disease-related targets were conducted through DrugBank (https://go.drugbank.com/), Pharm GKB (https://www.pharmgkb.org/), TTD (https://db.idrblab.net/ttd/), OMIM (https://www.omim.org/) and GeneCards (https://www.genecards.org/) and other databases to screen anti-inflammatory and antibacterial targets, and online tools were used to create a Venn diagram to show the intersection of active components and disease targets17.
Constructing protein-protein (PPI) interaction network
The obtained intersection targets were input into the STRING database (http://string-db.org/) for protein-protein interaction (PPI) network analysis, and the species was limited to “Homo sapiens”, and the confidence value was greater than 0.4.18 The PPI network was constructed by Cytoscape 3.10.0 software. In addition, the CytoNCA plug-in of Cytoscape software was used to sort the values from high to low and screen the key core targets. These analyses were helpful to understand how the active components of Shengli grass exert anti-inflammatory and antibacterial effects through its target, and reveal its potential therapeutic mechanism.
Enrichment analysis of GO and KEGG pathways
The intersection target of active ingredients and diseases was introduced into the database of David (https://davidbioloinformatics.nih.gov/tools.jsp), and selected from Cellular Component (CC), Molecular Function, (MF) and Biological Process (BP) were used to analyze the GO biological function enrichment of the intersection target of the active components and antibacterial and anti-inflammatory, and the KEGG pathway enrichment was selected for the annotation analysis of the target gene pathway19.
Construction of network
To further probe the multi-scale mechanisms of action underlying multiple pharmacological effects of Shengli grass, a compound-target-disease network (C-T-D network) and target-pathway network (T-P network) were separately established to systematically elucidate the complicated relationships among bioactive compounds, targets, diseases, and pathways. The C-T-D network was constructed by connecting the potential active compounds with their candidate targets and related diseases. The T-P network was built by linking the related targets and their corresponding pathways. All these visualized networks were constructed using Cytoscape3.10.0, a popular bioinformatics package for the visualization and integration of biological network data20.
Statistical analysis
All the experimentations were done in triplicates. The GC-MS detection results were analyzed based on the peak area normalization method. First, qualitative identification was performed by matching with the NIST2.0 L database, and then Microsoft Excel 2021 was used to analyze the mass spectrometry data of the relative content of each component. PCA analysis were made by using SPSS 27.0.1 and Origin 2021.
Results
Isolation purification and identification of endophytic bacteria from Shengli grass
Eleven dominant endophytic bacteria (Fig. 2) were obtained from the roots stems and leaves of Shengli grass, including 4 strains in roots (R15, R24, R40, R50), 5 strains in stems (S26, S28, S33, S50, S51) and 2 strains in leaves (L48, L59).
The 16 S rRNA gene of 11 strains was sequenced to obtain a DNA fragment with a size of 1 500 bp. The sequenced sequences were submitted to GenBank, and the sequence numbers were R15(PQ669021), R24(PQ668643), R40(PQ668647), R50(PQ668648), S26(PQ668649), S28(PQ774786), S33(PQ668650), S50(PQ668653), S51(PQ668816), L48(PQ668818) and L59(PQ668819) respectively. The phylogenetic tree was constructed by using the model strain sequences (Fig. 3). The results of phylogenetic tree and DNAMAN comparison showed that strain R15 and Bacillus pumilus were on the same branch, and the matching degree reached 95.75%. Strains R24, R50 and S33 were 98.75%, 98.90% and 99.12% identical with Agrobacterium tomkonis on the branch of Agrobacterium, and the matching degree between S28 and Agrobacterium salinitolerans was 100%. The matching degree between L48 and Pseudomonas chlororaphis reached 97.71%. Strains R40, S26, S50, S51 and L59 are all more than 94% identical with Acinetobacter oryzae. To sum up, strain R15 belongs to Bacillus pumilus; R24, R50 and S33 belong to Agrobacterium tomkonis; S28 belongs to Agrobacterium salinitolerans; L48 belongs to Pseudomonas chlororaphis; R40, S26, S50, S51 and L59 belong to Acinetobacter oryzae (Fig. 3).
Endophytic bacterial colony of Shengli grass.
Phylogenetic tree constructed based on 16 S rDNA sequences of 11 endophytic bacteria.
Identification of volatile components in Shengli grass
The volatile organic compounds (VOCs) of Shengli grass were determined by HS-SPME and GC-MS. Compared with NIST20.L database and referring to related literature reports, 100 components were identified. Detailed results were shown in Table 2.These volatile organic compounds included terpenes (38), esters (20), alcohols (10), aldehydes (9), aromatics (8), ketones (4), acids (4) and phenols (2).
A total of 43 compounds were identified from the roots of Shengli grass, there are many kinds of olefins, esters and aldehydes, and the contents of olefins, esters and aromatic compounds are higher than other kinds, including γ-Himachalene (18.89%), Bornyl acetate (8.90%), (Z)-γ-bisabolene (7.04%) and isocaryophyllene (6.93%) and other components are relatively high, which is the main component. A total of 41 compounds were identified from the stems of the plant, and terpenes, esters and aromatic compounds were relatively high in quantity and relative content. selina-3,7(11)-diene (29.50%), linalyl propionate (17.19%), m-cymene (13.77) and melonal (12.45%) are the main components of the stem. A total of 41 compounds and the main components in the leaves were m-cymene (26.17%), selina-3,7 (11)-diene (20.84%), γ-selinene (12.74%) and α-phellandrene (7.14%), which were mainly terpenes, esters and aromatic compounds.
For terpenes, esters and aromatic, phenolic acids, and coumarin, a similar program was performed on tentative identification with relative literature21,22,23,24,25,26,27,28,29. Although significant efforts were made, eight compounds could not yet be characterized and were thus assigned as unknown compounds. By GC-MS component identification, we obtained 92 components identical to those reported in the literature. To ensure the integrity of the data, a total of 100 compounds were obtained. We used 100 compounds as a material database for further screening.
Unsupervised Principal Component Analysis (PCA) was performed on the 100 metabolites detected in the volatile gases of Shengli grass, and the PCA plot is shown in Fig. 4. Based on the magnitude of eigenvalues, the eigenvector explaining the largest variance was selected as the first principal component (PC1), and the eigenvector explaining the second-largest variance was selected as the second principal component (PC2). The two principal components (PC1 and PC2) accounted for 98.1% of the total variance in the entire dataset across different tissues. The PCA plot indicated that there were certain differences among the components in different tissues, with relatively distinct separation.
Principal component analysis (PCA) of chemical constituents in volatile gases from different tissues of Shengli Grass.
Identification of chemical constituents in the extract of Shengli grass
51 components were identified from the ethyl acetate extract of Shengli grass by SPME-GC-MS technology (Table 3), among which 12, 24 and 28 components were identified from the roots, stems and leaves respectively, and esters were relatively high in species and content.
The content of Bis(2-ethylhexyl) adipat (5.48%) in the roots was high. Coumarin (35.55%), 2,3-dihydro-3,5-dihydro-6-methyl-4 h-pyran-4-one (7.58%), acetic acid (7.42%) and o-methyl thymol (5.01%) were found in the stems. Coumarin (28.83%) was also very high in leaves, followed by hydrocumarin (5.27%), pentanal (4.59%) and isovaleraldehyde (4.54%).
Unsupervised Principal Component Analysis (PCA) was conducted on the 51 metabolites detected in the ethyl acetate extract of Shengli grass, and the PCA plot is presented in Fig. 5. The two principal components (PC1 and PC2) explained 99% of the total variance in the entire dataset across different tissues. The PCA plot indicated that there were certain differences among the components in different tissues, showing relatively distinct separation.
Principal component analysis (PCA) of chemical constituents in ethyl acetate extracts from different tissues of Shengli Grass.
Analysis of secondary metabolites of endophytes in Shengli grass
In the current study, 24 compounds from ethyl acetate crude extracts of bacterial endophytes were identified and isolated from Shengli grass, including 6 acids, 4 esters, 4 aromatics, 3 ketones, 2 alcohols, 2 aldehydes, 2 phenols, and 1 ether (Table 4). The compounds identified from R50 (10) are the most, followed by S26 (9), S50 (8) and S51 (8). Esters were relatively high in the secondary metabolites of strains R15, R24, R50, S26, S33 and L48, whereas acids and Esters were relatively high in strains R40, S28, S50 and S51, and acids was relatively high in strain L59. Bis(2-ethylhexyl) adipate can be found in R15 (8.43%), R24 (6.95%), R40 (3.62%), R50 (5.49%), S26 (6.99%), S28 (3.95%), S33 (6.93%), S50 (5.39%), S51 (5.36%) and L48 (7.63%), none of these compounds were found in L59, which instead had the highest levels of 4-Hydroxyphenylacetic acid (6.06%).
Among the 24 active products we obtained, 24 were found in the literature to exhibit antibacterial and antioxidant activities, with examples including 4-hydroxyphenylacetic acid ,30 Propanoic acid,31 Isoacetovanillone,32 Xanthotoxol,33 Methyl,34 Psi-baptigen,35 Purpurogallin et al.36,37,38
Unsupervised principal component analysis (PCA) was performed on 69 metabolites detected in the ethyl acetate extracts of Herba Pteridis Multifidae Shengli grass and its endophytes, and the resulting PCA score plot is shown in Fig. 6. The two principal components (PC1 and PC2) explained 59.2% of the total variance among different tissues in the entire dataset. The PCA plot results indicated that there were certain differences in the active components between Herba Pteridis Multifidae and its endophytes, which was reflected as a relatively obvious separation trend in the plot.
Principal component analysis (PCA) of chemical constituents in ethyl acetate extracts of secondary metabolites from different tissues of Shengli grass and its endophytes.
Screening and network pharmacological analysis of active ingredients in Shengli grass
Screening of active components and corresponding disease targets of Shengli grass
Among the volatile gases of Shengli Grass (with 100 components identified in total), 7 components—namely Selina-3,7(11)-diene, α-phellandene, o-cymene, o-acetyl-p-cresol, hexanal, 1-hexene, and (Z)-γ-bisabolene—were present in the roots, stems, and leaves simultaneously (Fig. 7A). Among the 51 components obtained from the ethyl acetate extraction of Shengli Grass, 22 volatile components (including coumarin, α-phenylalanine, and thymol) were found to coexist (Fig. 7B). Through comparative analysis, it was discovered that 7 metabolites of the endophytes were identical to the chemical components of Shengli Grass, consisting of 3 volatile components and 6 extract components (with 2 compounds present in all three plant tissues) (Fig. 7C). These shared metabolites account for 29% of the total metabolites of the endophytes. Notably, very few similar compounds have been identified in the characterization of secondary metabolites between endophytes and plants; therefore, further research is required to explore whether the metabolites of endophytes affect the active products of the host plant.
After TCMSP database screening, 110 chemical components (including 81 volatile components, 29 extract components) and 20 secondary metabolites were selected as network pharmacological research objects, corresponding to 418 and 223 targets respectively and 193 intersection targets existed among them (Fig. 7D). A total of 16,768 targets related to anti-inflammatory and 2265 targets related to antimicrobial were screened from DrugBank, TTD and GeneCards databases. There were 393 interlocking targets with inflammation and 152 interlocking targets with anti-bacterial. Endophytic metabolites had 315 interlocking targets with inflammatory and 132 interlocking targets with anti-bacterial activities (Fig. 7E).
(A) Venn diagram of the natural active ingredients of Shenli grass obtained using different methods ((a) Venn diagram of VOCs in shengli grass; (b) Venn diagram of ethyl acetate extraction of the active ingredient in Shengli grass); (B) Venn diagram of VOCs and active ingredients extracted with ethyl acetate of Shengli grass; (C) Venn diagram of natural active ingredients of Shengli grass and secondary metabolites of endophytes from Shengli grass; (D) Venn diagram of targets of natural active ingredients from Shengli grass and targets of secondary metabolites from its endophytes; (E) Venn diagram of anti-inflammatory and antibacterial targets of active ingredients from Shengli grass and its endophytes ((a) Venn diagram of targets between Shengli grass compounds and antibacterial effects; (b) Venn diagram of targets between Shengli grass compounds and inflammation; (c) Venn diagram of targets between endophytic metabolites and antibacterial effects; (d) Venn diagram of targets between endophytic metabolites and inflammation.)
PPI network construction and analysis
The intersection targets are imported into String database to construct PPI network (Fig. 8). Cytoscape3.10.0 was used to redraw the PPI network (Fig. 9). The darker the node color in the figure, the greater the influence on antibacterial or anti-inflammatory effect, which is the key core target. The core anti-bacterial targets of shengli grass included ALB, AKT1, CASP3, BCL2 and EGFR; the core anti-bacterial targets of endophytes were TNF, AKT1, ALB, NFKB1 and EGFR; the core anti-inflammatory targets of Shengli grass included AKT1, SRC, ALB, EGFR, CASP3, BCL2, ESR1 and NFKB1; and the core anti-inflammatory targets of endophytes were AKT1, SRC, ALB, EGFR, ESR1 and NFKB1. Four central genes (ALB, AKT1, SRC, EGFR, NFKB1) were identified, and they existed in the grass and endophyte.
Diagram of protein-protein interaction (PPI) network from the String database. (a) and (b) were anti-bacterial and anti-inflammatory of Shengli grass active components respectively. (c) and (d) are anti-bacterial and anti-inflammatory of endophytic bacteria active components, respectively.
The innermost node is the key target in the PPI network diagram after Cytoscape processing. (a) and (b) were anti-bacterial and anti-inflammatory of Shengli grass active components respectively. (c) and (d) are anti-bacterial and anti-inflammatory of endophytic bacteria active components, respectively.
Enrichment analysis of GO and KEGG
The intersection genes were imported into DAVID database for GO and KEGG analysis. The annotation results of Biological Process (BP), Cell Component (CC) and Molecular Function (MF) were shown in Table 5 Finally, the top 10 GO enrichment results and the top 10 KEGG signal pathways were screened out for graphic analysis. Among them, the antibacterial BP of shengli grass mainly involves in collagen catabolic process, response to xenobiotic simulation, extracellular matrix disassembly, etc. CC mainly resides in cytosol, cytoplasm, plasma membrane, etc.; MF mainly involves in enzyme binding, protein kinase activity, endopeptidase activity and so on (Fig. 10a). The anti-inflammatory BP of Shengli grass mainly involves in protein phosphorylation, G protein-coupled receptor signaling pathway, and responses to xenobiotic stimulation, etc. CC mainly resides in plasma membrane, dendrite, postsynaptic membrane, etc. MF mainly involves in protein tyrosine kinase activity, nuclear receptor activity, G protein-coupled serotonin receptor activity and so on (Fig. 10b). Anti-bacterial BP of endophytic bacteria in Shengli grass mainly involves in phosphorylation, protein phosphorylation, response to lipopolysaccharide, etc. CC mainly exists in cytosol, cytoplasm, external side of plasma membrane, etc. MF mainly involves in enzyme binding, ATP binding, protein tyrosine kinase activity and so on (Fig. 10c). The anti-inflammatory BP of endophytic bacteria in Shengli grass mainly involves in protein phosphorylation, phosphorylation, peptide-tyrosine phosphorylation, etc. CC mainly resides in plasma membrane, cytosol, cytoplasm, etc. MF mainly involves in protein tyrosine kinase activity, protein serine/threonine kinase activity, protein serine kinase activity and so on (Fig. 10d). Pathways in cancer are related to anti-bacterial and anti-inflammatory, and anti-bacterial related pathways include Endocrine resistance, lipid and atherosclerosis, etc. (Fig. 11a, c). The pathways related to anti-inflammation include neuroactive ligand-receptor interaction, Inflammatory mediator regulation of TRP channels, etc. (Fig. 11b, d).
Bar chart of annotation analysis of Gene Ontology (GO). (a) and (b) were anti-bacterial and anti-inflammatory of Shengli grass active components respectively. (c) and (d) are anti-bacterial and anti-inflammatory of endophytic bacteria active components, respectively.
Network construction and analysis
To further probe the multi-scale mechanisms of action underlying multiple pharmacological effects of Shengli grass and endophyte, a compound-target-disease network (C-T-D network) and target-pathway network (T-P network) were separately established to systematically elucidate the complicated relationships among bioactive compounds, targets, diseases, and pathways.
Compound-target-disease network analysis
Compound-target-disease network analysis was conducted to uncover the therapeutic mechanisms of Shengli grass in the treatment of related diseases, the compound-target-disease network (C-T-D) network. There were 75 volatile components, 38 extract components, 16 endophytic metabolites and 206 protein targets related to antibacterial activity (Fig. 12a). There were 81 volatile components, 45 extract components, 20 endophytic metabolites and 523 protein targets related to anti-inflammation (Fig. 12b). C-T-D network showed 106 components and 206 protein targets related to antibacterial activity. Geranyl isobutyrate (B14), neryl acetate (A21/B30), neryl butyrate (B10), neryl isovalerate (A73), geranyl propionate (A39), geranyl isovalerate (A30), cis-3-hexenyl butyrate (A51), flopropione (B47), bis(2-ethylhexyl) adipate (B4/C1) and neryl formate (A26/B40) were linked to 37, 35, 34, 32, 30, 29, 25, 23, 22 and 21 targets, respectively, and constituted the main components of the plant. C-T-D network showed that 118 compounds and 523 protein targets were related to anti-inflammatory diseases. Geranyl isobutyrate (B14), neryl butyrate (B10), neryl isovalerate (A73), neryl acetate (A21/B30), geranyl propionate (A39), geranyl isovalerate (A30), cis-3-hexenyl butyrate (A51), neryl propionate (A25), neryl formate (A26/B40), bis(2-ethylhexyl) adipate (B4/C1) and n-benzyl-2-phenethylamine (B11) were linked to 100, 96, 94, 93, 82, 78, 77, 57, 56, 52 and 51 targets, respectively, and constituted the main components of Shengli grass.
C-T-D network. Blue, yellow and green round nodes represent compounds, red triangular nodes represent diseases, and purple V-shaped nodes represent targets.
Target-pathway (T-P) network analysis
The T-P network of anti-bacterial (Fig. 13a, c) and anti-inflammatory (Fig. 13b, d) activities of Shengli grass was constructed by using the pathways and related genes obtained from KEGG enrichment analysis. The diagram showed those significantly enriched pathways, which were closely related to disease-related targets. For example, pathway in cancer showed the highest number of connections with anti-bacterial related genes, as followed by the lipid and atherosclerosis signaling pathway. The key pathways related to the anti-inflammatory activity of Shengli grass are neuroactive ligand-receptor interaction, pathways in cancer and calcium signaling pathway; and the key pathways related to endophytic bacteria anti-inflammation are phosphorylation, protein phosphorylation and response to xenobiotic stimulation.
The main chemical constituents related to the anti-bacterial effect of shengli grass were geranyl isobutyrate (B14), neryl acetate (A21/B30), neryl butyrate (B10), neryl isovalerate (A73) and geranyl propionate (A39), geranylisovalerate (A30), cis-3-hexynyl Butyrate (A51), flopropione (B47), bis (2-ethylhexyl) adipate (B4/C1) and neryl format (A26/B40), and the related core targets are ALB, AKT1, CASP3, BCL2, EGFR, SRC, NFKB1, PTGS2, MMP9 and ESR1. The chemical constituents related to anti-inflammatory effects were geranyl isobutyrate (B14), neryl butyrate (B10), neryl isovalerate (A73), neryl acetate (A21/B30) and geranyl propionate (A39), geranyl isovalerate (A30), cis-3-hexenyl butyrate (A51), neryl propionate (A25), neryl formate (A26/B40), bis (2-ethylxyl) adipate (B4/C1) and n-benzyl-2-phenethhylamine (B11), and the corresponding core targets of the compounds are AKT1, SRC, ALB, EGFR, ESR1, NFKB1, PTGS2 and MMP9. ALB, which codes for the protein albumin, is involved in the transport of various substances throughout the body, including drugs and toxins. For instance, albumin has also been shown to exert antimicrobial effects, as it can bind to and neutralize bacterial toxins42. MMP9 and MMP2 are matrix metalloproteinases that are involved in tissue remodeling and are thought to play a role in hosts’ responses to bacterial infections43. AKT1 is a serine/threonine protein kinase with apoptosis-inhibiting and metabolism-regulating effects. Studies showed that AKT1 is associated with several bacterial infection pathways. For example, by activating the PI3K/Akt1/mTOR signaling pathway, Mycobacterium tuberculosis can induce M2 polarisation in macrophages and interfere with the host immune response44. EGFR is associated with tumor development, immune regulation, and apoptosis45. It is speculated that these targets might be the key action targets for the active ingredients of Shengli grass to exert anti-bacterial and anti-inflammatory effects. These results suggested that the active ingredients of Shengli grass might exert antibacterial and antiviral effects through multiple signaling pathways, and the antibacterial and anti-inflammatory pathways might be shared.
T-P network. (a) and (b) were anti-bacterial and anti-inflammatory of Shengli grass active components respectively. (c) and (d) are anti-bacterial and anti-inflammatory of endophytic bacteria active components, respectively. V nodes represent diseases, triangle nodes represent pathways, and circle nodes represent targets.
Discussion
Among the compounds of Shengli grass itself, its volatile components exhibit distinct family- and genus-specific chemotaxonomic marker characteristics. For example, the sesquiterpenoids Selina-3,7(11)-diene and (Z)-γ-bisabolene possess group specificity within Asteraceae. Previous studies have shown that Selina-type sesquiterpenoids are characteristic metabolites of Asteraceae plants, and the structural conservation of their skeletons serves as chemical evidence for classifying Shengli Grass under Asteraceae. Additionally, the monoterpenoid α-phellandene and the aromatic compound o-cymene are distributed in angiosperms including Asteraceae, which further confirms Shengli Grass’ taxonomic status as an Asteraceae plan46. Meanwhile, this phenomenon reflects the potential convergent evolution in volatile terpenoid biosynthesis pathways across different plant groups—for instance, the production of monoterpenoids via catalysis by similar terpene synthases.
More evolutionarily significant is the discovery of 7 shared metabolites between Shengli grass and its endophytes (including 3 volatile components, 6 ethyl acetate extract components, and 2 components common across all three plant tissues), which reveals the “metabolic convergence” or “metabolic interaction” mechanisms underlying the long-term coevolution of the host and endophytes47. For instance, coumarins (e.g., xanthotoxol), as metabolites shared by Shengli grass and its endophytes, serve as defensive metabolic markers for Asteraceae plants in chemotaxonomy. Existing studies have demonstrated that endophytic fungi isolated from medicinal plants can produce components shared with their host plants. A case in point is that Alternaria alternata isolated from Taxus chinensis var. mairei is capable of producing Taxol48. This phenomenon of shared compounds is most likely the result of endophytes acquiring key genes for coumarin biosynthesis from the host via “horizontal gene transfer”; alternatively, it may reflect the convergent selection of similar metabolic pathways by both the host and endophytes under evolutionary pressure (e.g., in response to invasion by external pathogens). Ultimately, this gives rise to the symbiotic advantage of “host-endophyte metabolic complementarity”.
These compound-based evidences not only provide supplementary verification for the chemotaxonomic affiliation of Shengli grass in Asteraceae family, but also link the metabolic characteristics of a single plant to the taxonomic association of endophytes (e.g., endophytes capable of synthesizing coumarins and terpenyl esters may belong to specific bacterial groups) and the metabolic mechanisms of host-microbe symbiotic evolution. This offers a new direction for subsequent studies on resolving the phylogenetic relationships between ferns and endophytes from a chemical perspective and exploring the evolutionary adaptability of symbiotic systems.
Data availability
Data will be made available on request. The datasets generated and/or analysed during the current study are available in the NCBI repository (https://www.ncbi.nlm.nih.gov/), R15 (PQ669021), R24 (PQ668643), R40 (PQ668647), R50 (PQ668648), S26 (PQ668649), S28 (PQ684257), S33 (PQ668650), S50 (PQ668653), S51 (PQ668816), L48 (PQ668818), L59 (PQ668819).
References
Wang, L. & Fu, S. Study on Pharmacological action of Shanglicao water Decoction. Heilongjiang J. Anim. Sci. Vet. Med. (21), 158–159. (2013). (in Chinese).
Zhang, C. M. et al. The Anti-fatigue effect of Shanglicao in mice. Contemp. Anim. Husb. (05), 28–30. (2021). (in Chinese).
Wang, L. & Fu, S. Effect of Shanglicao Decoction on rat immune function of mice. J. Henan Agr Sci. (3), 147–149 (2014). (in Chinese).
Wang, L. & Yang, Y. L. Effects of Shengli grass Decoction on some serum biochemical indices of broilers. Heilongjiang J. Anim. Sci. Vet. Med. 19, 166–169 (2018). (in Chinese).
Wang, L. & Ding, S. H. Observation on the prevention and treatment effect of Shengli grass Decoction on infectious bronchitis of artificially infected chickens. Feed Rev. 11, 61–62 (2019). (in Chinese).
Wang, L. & Yang, Y. L. Acute toxicity test of water extract of Shengli grass on broilers. Heilongjiang J. Anim. Sci. Vet. Med. (24):133–135. (2019). (in Chinese).
Xu, Y. J. et al. Inhibitory effects of water extracts of medicinal plant Shengli grass on Escherichia coli by response surface analysis. China Brew. (05), 169–173. (2022). (in Chinese).
Pal, K. K. et al. Alleviation of Salinity Stress in Peanut by Application of Endophytic.
Gupta, S., Chaturvedi, P., Kulkarni, M. G. & Van Staden, J. A critical review on exploiting the pharmaceutical potential of plant endophytic fungi. Biotechnol. Adv. 39, 107462 (2020).
Li, Z. et al. Biosynthetic mechanisms of secondary metabolites promoted by the interaction between endophytes and plant hosts. Front. Microbiol. 13, 928967 (2022).
Neilan, B. A., Jacobs, D. & Goodman, A. E. Genetic diversity and phylogeny of toxic cyanobacteria determined by DNA polymorphisms within the phycocyanin locus. Appl. AEM. 61 (11), 3875–3883 (1995).
Gupta, P., Dhanya, A. J., Sharma, R. & Sreelakshmi, Y. Identification of Volatiles in Tomato Fruit Using Headspace Solid-Phase-Micro-Extraction (HS-SPME) Coupled with Gas Chromatography-Mass Spectrometry (GC-MS). Methods Mol. Biol. (Clifton, N.J.). (2024).
Li, R. et al. Diversity and correlation analysis of endophytes and metabolites of Panax Quinquefolius L. in various tissues. BMC Plant. Biol. 23 (1), 275 (2023).
Kalita, H. et al. Antibacterial activity and GC-MS profiling of Stephania glandulifera Miers root extract. Vegetos 1–10. (2024).
Liu, Y. et al. Isolation and identification of endophytic bacteria in Paris Qiliangiana and study on their secondary metabolites. Shandong Agri Sci. 55 (4), 73–82 (2023).
Long, Y., Tuvshinjargal, T. & Perenlei, M. E. Network Pharmacology of Mongolian medicine Ran Agar-8. Int. J. Clin. Exp. Med. 8 (3), 442–449 (2024).
Chang, X. et al. Taoren Honghua Decoction alleviates atherosclerosis by inducing autophagy and inhibiting the PI3K-AKT signaling pathway to regulate cholesterol efflux and inflammatory responses. Int. Immunopharmacol. 144, 113629 (2025).
Wang, N., Tang, L., Duan, R. & Shu, Y. Investigating the mechanism of hedysarum multijugum Maxim in the treatment of liver cancer through network Pharmacology and molecular Docking validation. Oncology 1–24. (2024).
Zhao, X., Xiu, J., Yang, H., Han, W. & Jin, Y. Network Pharmacology and bioinformatics study of six medicinal food homologous plants against colorectal cancer. Int. J. Mol. Sci. 26 (3), 930 (2025).
Yadav, V., Pandey, V., Gaglani, P. & Srivastava, A. Network Pharmacology and molecular Docking insights into Sirtuin-2 inhibitors (AK-7 and AGK-2): A synergistic strategy for COPD treatment. Hum. Genet. 201360. (2024).
Bankova, V., Christov, R., Kujumgiev, A., Marcucci, M. C. & Popov, S. Chemical composition and antibacterial activity of Brazilian propolis. Z. Naturforsch C. 50 (3–4), 167–172 (1995).
El-Ashmawy, I. M., Aljohani, A. S. M. & Soliman, A. S. Studying the bioactive components and phytochemicals of the methanol extract of Rhanterium epapposum Oliv. Appl. Biochem. Biotechnol. 196 (5), 2414–2424 (2024).
Nurcholis, W. et al. Comparative analysis of volatile compounds and biochemical activity of curcuma xanthorrhiza Roxb. Essential oil extracted from distinct shaded plants. Plants 13 (19), 2682 (2024).
Horiuchi, J. I., Muroi, A., Takabayashi, J. & Nishioka, T. Exposing Arabidopsis seedlings to Borneol and Bornyl acetate affects root growth: specificity due to the chemical and optical structures of the compounds. J. Plant. Interact. 2 (2), 101–104 (2007).
Zhang, J. H., Sun, H. L., Chen, S. Y., Zeng, L. I. & Wang, T. T. Anti-fungal activity, mechanism studies on α-Phellandrene and Nonanal against penicillium cyclopium. Bot. Stud. 58, 1–9 (2017).
Noge, K., Becerra, J. X. & Germacrene, D. A common sesquiterpene in the genus BurserA (Burseraceae). Molecules 14 (12), 5289–5297 (2009).
Marchese, A. et al. Antibacterial and antifungal activities of thymol: A brief review of the literature. Food Chem. 210, 402–414 (2016).
Bailén, M. et al. Anti-Trypanosomatidae activity of essential oils and their main components from selected medicinal plants. Molecules 28 (3), 1467 (2023).
Quiroga, P. R., Nepote, V. & Baumgartner, M. T. Contribution of organic acids to α-terpinene antioxidant activity. Food Chem. 277, 267–272 (2019).
Zhao, H. et al. 4-Hydroxyphenylacetic acid prevents acute APAP-induced liver injury by increasing phase II and antioxidant enzymes in mice. Front. Pharmacol. 9, 653 (2018).
Dupati, P., Sapuri-Butti, A. R., Thumma, V. & Boddu, L. S. Synthesis of new 3-(Benzo [d] Oxazol-2-Yl)-3-(4-Fluorophenyl) propanoic acid intermediate and its derivatives as antimicrobial Agent, molecular Docking studies. Chem. Afr. 1–16. (2024).
Minaiyan, M., Asghari, G., Sadraei, H. & Feili, E. Anti-inflammatory effect of pycnocycla spinosa extract and its component Isoacetovanillone on acetic acid induced colitis in rats. Res. Pharm. Sci. 10 (4), 345–355 (2015).
Ma, Z. et al. Metabolism and metabolic inhibition of xanthotoxol in human liver microsomes. Evid. Based Complementary Altern. Med. 2016, (1), 5416509 (2016).
Balachandran, C. et al. Antimicrobial and antimycobacterial activities of Methyl caffeate isolated from solanum torvum Swartz. Fruit. Indian J. Microbiol. 52, 676–681 (2012).
Jeevanandam, J., Madhumitha, R. & Saraswathi, N. T. Identification of potential phytochemical lead against diabetic cataract: an insilico approach. J. Mol. Struct. 1226, 129428 (2021).
Park, H. Y. et al. Purpurogallin exerts anti–inflammatory effects in lipopolysaccharide–stimulated BV2 microglial cells through the inactivation of the NF–κB and MAPK signaling pathways. Int. J. Mol. Med. 32 (5), 1171–1178 (2013).
Chang, C. Z., Lin, C. L., Wu, S. C. & Kwan, A. L. Purpurogallin, a natural Phenol, attenuates High-Mobility group box 1 in subarachnoid hemorrhage induced vasospasm in a rat model. Int. J. Vasc Med. (1), 254270. (2014).
Honda, S., Fukuyama, Y., Nishiwaki, H., Masuda, A. & Masuda, T. Conversion to purpurogallin, a key step in the mechanism of the potent Xanthine oxidase inhibitory activity of pyrogallol. Free Radic Biol. Med. 106, 228–235 (2017).
Kanehisa, M., Furumichi, M., Sato, Y., Matsuura, Y. & Ishiguro-Watanabe, M. KEGG: biological systems database as a model of the real world. Nucleic Acids Res. 53, D672–D677 (2025).
Kanehisa, M. Toward Understanding the origin and evolution of cellular organisms. Protein Sci. 28, 1947–1951 (2019).
Kanehisa, M. & Goto, S. KEGG: Kyoto encyclopedia of genes and genomes. Nucleic Acids Res. 28, 27–30 (2000).
Wiedermann, C. J. Hypoalbuminemia as surrogate and culprit of infections. Int. J. Mol. Sci. 22 (9), 4496 (2021).
Vanlaere, I. & Libert, C. Matrix metalloproteinases as drug targets in infections caused by gram-negative bacteria and in septic shock. Clin. Microbiol. Rev. 22 (2), 224–239 (2009).
Sha, S. et al. Mycobacterium tuberculosis Rv1987 protein induces M2 polarization of macrophages through activating the PI3K/Akt1/mTOR signaling pathway. Immunol. Cell. Biol. 99 (6), 570–585 (2021).
Li, C. C., Yuan, N. N., Bai, H. F., Wang, Y. & Wei, L. Sun, L. X. Prediction of quality markers for Xiaoyan Tuire granules based on HPLC fingerprint and network Pharmacology. CTHD 52, 3885–3895 (2021).
Sílvia, M. F., Bessada, João, C. M. & Barreira, M. Oliveira,Asteraceae species with most prominent bioactivity and their potential applications: A review. Ind. Crops Prod. 76, 604–661 (2015).
Alam, B. et al. Endophytic fungi: from symbiosis to secondary metabolite communications or vice versa? Front. Plant. Sci. 12, 791033 (2021).
Oberhofer, M. et al. Biosynthetic Potential of the Endophytic Fungus Helotiales sp. BL73 Revealed via Compound Identification and Genome Mining. Appl Envi.
Funding
The authors would like to acknowledge the support provided by the National Natural Science Foundation of China (U1204301), Key Scientific Research Program of Henan University (24A180022) and The National Undergraduate Innovation and Entrepreneurship Training Program (202510483014X, 202510483015X). In addition, this work has received no outside funding.
Author information
Authors and Affiliations
Contributions
Longfei Zhao: Conceptualization and funding acquisition. Xuezhen Huang: Data curation and writing-original draft. Yajun Xu: Formal analysis and investigation. Li Xi: Formal analysis and investigation. Weiyi Song: Writing-review&editing. Xiaolong Xing: Writing-review & editing, Methodology, Formal analysis. Mengjie Liu, Min Li and Yiting Hou: Writing-review&editing.
Corresponding author
Ethics declarations
Competing interests
The authors declare no competing interests.
Additional information
Publisher’s note
Springer Nature remains neutral with regard to jurisdictional claims in published maps and institutional affiliations.
Supplementary Information
Below is the link to the electronic supplementary material.
Rights and permissions
Open Access This article is licensed under a Creative Commons Attribution-NonCommercial-NoDerivatives 4.0 International License, which permits any non-commercial use, sharing, distribution and reproduction in any medium or format, as long as you give appropriate credit to the original author(s) and the source, provide a link to the Creative Commons licence, and indicate if you modified the licensed material. You do not have permission under this licence to share adapted material derived from this article or parts of it. The images or other third party material in this article are included in the article’s Creative Commons licence, unless indicated otherwise in a credit line to the material. If material is not included in the article’s Creative Commons licence and your intended use is not permitted by statutory regulation or exceeds the permitted use, you will need to obtain permission directly from the copyright holder. To view a copy of this licence, visit http://creativecommons.org/licenses/by-nc-nd/4.0/.
About this article
Cite this article
Zhao, L., Huang, X., Xu, Y. et al. Network pharmacological prediction of chemical constituents and endophyte metabolites of medicinal plant Shengli grass. Sci Rep 15, 36919 (2025). https://doi.org/10.1038/s41598-025-20961-3
Received:
Accepted:
Published:
Version of record:
DOI: https://doi.org/10.1038/s41598-025-20961-3